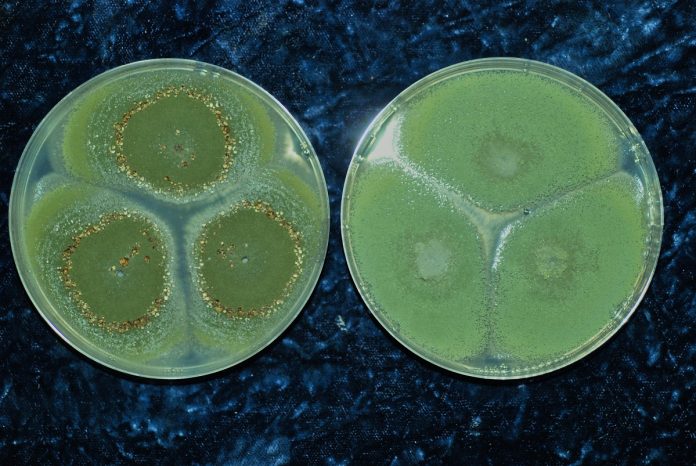

El uso generalizado de fungicidas azólicos (azoles) en la agricultura puede aumentar el riesgo de que los hongos del género Aspergillus desarrollen resistencia a los tratamientos médicos de la aspergilosis, una infección grave en humanos. Los azoles, además de en medicamentos esenciales, se utilizan ampliamente como fungicidas en el ámbito de la agricultura y la horticultura, como medicamentos veterinarios para tratar las micosis en animales, como biocidas en conservantes de la madera, como productos químicos industriales (p. ej., sustancias intermedias y colorantes) y en cosméticos (p. ej., productos anticaspa).
Por primera vez, las cinco agencias de salud y medioambientales de la Unión Europea, apoyadas por el Centro Común de Investigación (JRC) de la Comisión Europea, han examinado conjuntamente cómo afecta a la salud pública el uso de sustancias azólicas fuera de la medicina humana. EFSA (Autoridad Europea de Seguridad Alimentaria), ECDC (Centro Europeo para la Prevención y el Control de las Enfermedades), ECHA (Agencia Europea de Sustancias y Mezclas Químicas), AEMA (Agencia Europea de Medio Ambiente), EMA (Agencia Europea de Medicamentos) y el JRC han colaborado en el marco de la estrategia One Health (Una sola salud) para hacer frente a esta amenaza creciente.
El informe destaca que el uso generalizado de azoles fuera de la medicina humana, especialmente en la agricultura, contribuye al riesgo de que Aspergillus spp. desarrolle resistencias. Los datos recogidos detallan el uso de fungicidas azólicos en toda Europa. Los productos de protección fitosanitaria representan la mayor parte de las ventas notificadas en todos los sectores. “El impacto del uso de fungicidas azólicos en la agricultura y otros sectores ajenos a la medicina humana sobre la resistencia a los antifúngicos pone de manifiesto la necesidad crítica de equilibrar unas prácticas eficaces con la protección de la salud y el medio ambiente. El enfoque ‘Una sola salud’ nos permite aunar diversos conocimientos para hacer frente a este reto y salvaguardar la salud pública para las generaciones futuras”, ha declarado Bernhard Url, director ejecutivo en funciones de la EFSA.
Abordar la resistencia de este género de hongos a los azoles requiere una colaboración intersectorial. Por este motivo, el estudio reunió a expertos de la UE en medicina humana y veterinaria, agricultura y ciencias medioambientales para revisar los datos existentes, determinar los factores que favorecen la resistencia a los azoles y proponer medidas para prevenirla y controlarla.
Cinco agencias de salud y medioambientales de la UE, y el JRC de la Comisión Europea, han examinado cómo afecta a la salud pública el uso de sustancias azólicas
Los expertos de las agencias recomiendan añadir nuevos requisitos específicos a los procesos de aprobación y autorización de los fungicidas azólicos; apoyar la investigación y el desarrollo de nuevos fungicidas con mecanismos de acción innovadores que no den lugar a resistencia a los antifúngicos utilizados en los tratamientos destinados a seres humanos; seguir buenas prácticas de agricultura y horticultura, almacenar adecuadamente los residuos orgánicos, gestionar eficazmente los residuos y utilizar y eliminar de forma responsable los productos tratados con azoles; aplicar una gestión eficaz de los residuos de la madera tratada con biocidas a base de azoles; recoger más datos sobre los usos de los fungicidas azólicos y de los antifúngicos azólicos; seguir desarrollando guías técnicas específicas y metodologías de evaluación de riesgos para apoyar las decisiones reglamentarias sobre la aprobación de sustancias azólicas y para mitigar el riesgo de resistencia de Aspergillus a los azoles; y realizar más investigaciones para responder a las incertidumbres existentes.
La UE subraya que el informe “refuerza el valor de la estrategia ‘Una sola salud’ a la hora de abordar amenazas complejas para la salud, como la resistencia a los antifúngicos. Mediante la colaboración interdisciplinar continua, podemos reforzar la vigilancia, impulsar la investigación y aplicar medidas eficaces para proteger la salud pública, la sanidad animal y el medio ambiente”.